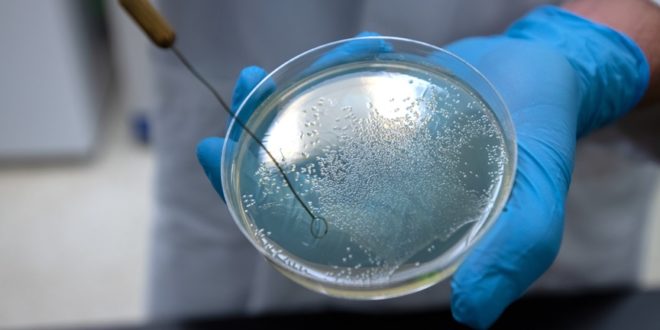

Některé z nejnebezpečnějších bakterií vyhledávají lidskou krev a živí se jí, Tuto nově objevenou vlastnost vědci označili přímo za bakteriální vampyrismus.
Tým vedený vědci z Washington State University zjistil, že bakterie přitahuje tekutá část krve – sérum, které obsahuje živiny (poznámka: složení zhruba odpovídá krevní plazmě), jež bakterie mohou využít jako potravu. Jednou z chemických látek, která bakterie v rámci prováděných experimentů obzvlášť přitahovala, byla aminokyselina serin. Výsledky výzkumu poskytují nový pohled na to, jak vznikají infekce krevního řečiště i jak by mohly být potenciálně léčeny.
„Zjistili jsme, že některé bakterie, které nejčastěji způsobují infekce krevního řečiště, vycítí serin v lidské krvi a plavou směrem k němu (poznámka: proti gradientu zřejmě míněno),“ uvádí spoluautor práce Arden Baylink. Jeho kolegyně Siena Glenn říká, že podle jejich výzkumu lidské krevní sérum přitahuje nejméně tři druhy bakterií: Salmonella enterica, Escherichia coli a Citrobacter koseri. Tyto bakterie jsou hlavní příčinou úmrtí lidí, kteří trpí zánětlivými střevními onemocněními – což se přitom týká asi 1 % populace. Tito pacienti mají často střevní krvácení, které může být pro bakterie vstupním místem do krevního oběhu.
Pomocí pokročilých technik mikroskopie vědci simulovali střevní krvácení vstříknutím mikroskopického množství lidského séra a pak pozorovali, jak se bakterie pohybují směrem ke zdroji. Jejich reakce byla rychlá – trvalo méně než minutu, než bakterie způsobující onemocnění sérum najdou.
V rámci studie vědci dále zjistili, že salmonely mají speciální proteinový receptor Tsr, který bakteriím umožňuje vycítit sérum a plavat k němu. Pomocí techniky zvané proteinová krystalografie se jim podařilo zobrazit atomy proteinu interagující se serinem. Výzkum by mohl vést k novým lékům, které by tyto schopnosti/fungování bakterií blokovaly.
Siena J. Glenn et al, Bacterial vampirism mediated through taxis to serum, eLife (2024). DOI: 10.7554/eLife.93178.2
Zdroj: Washington State University / Phys.org, přeloženo / zkráceno
Poznámka PH: V průvodní tiskové zprávě je trochu matoucí, že se vedle sebe mluví o séru obecně a o serinu (serin je od latinského sericum, hedvábí, se sérem to slovo asi nesouvisí). Navíc v krvi snad ani nejsou přítomné volné aminokyseliny, jen v proteinech, a že by zde serin měla nějak speciálně významné místo…?
 Sciencemag.cz
Sciencemag.cz